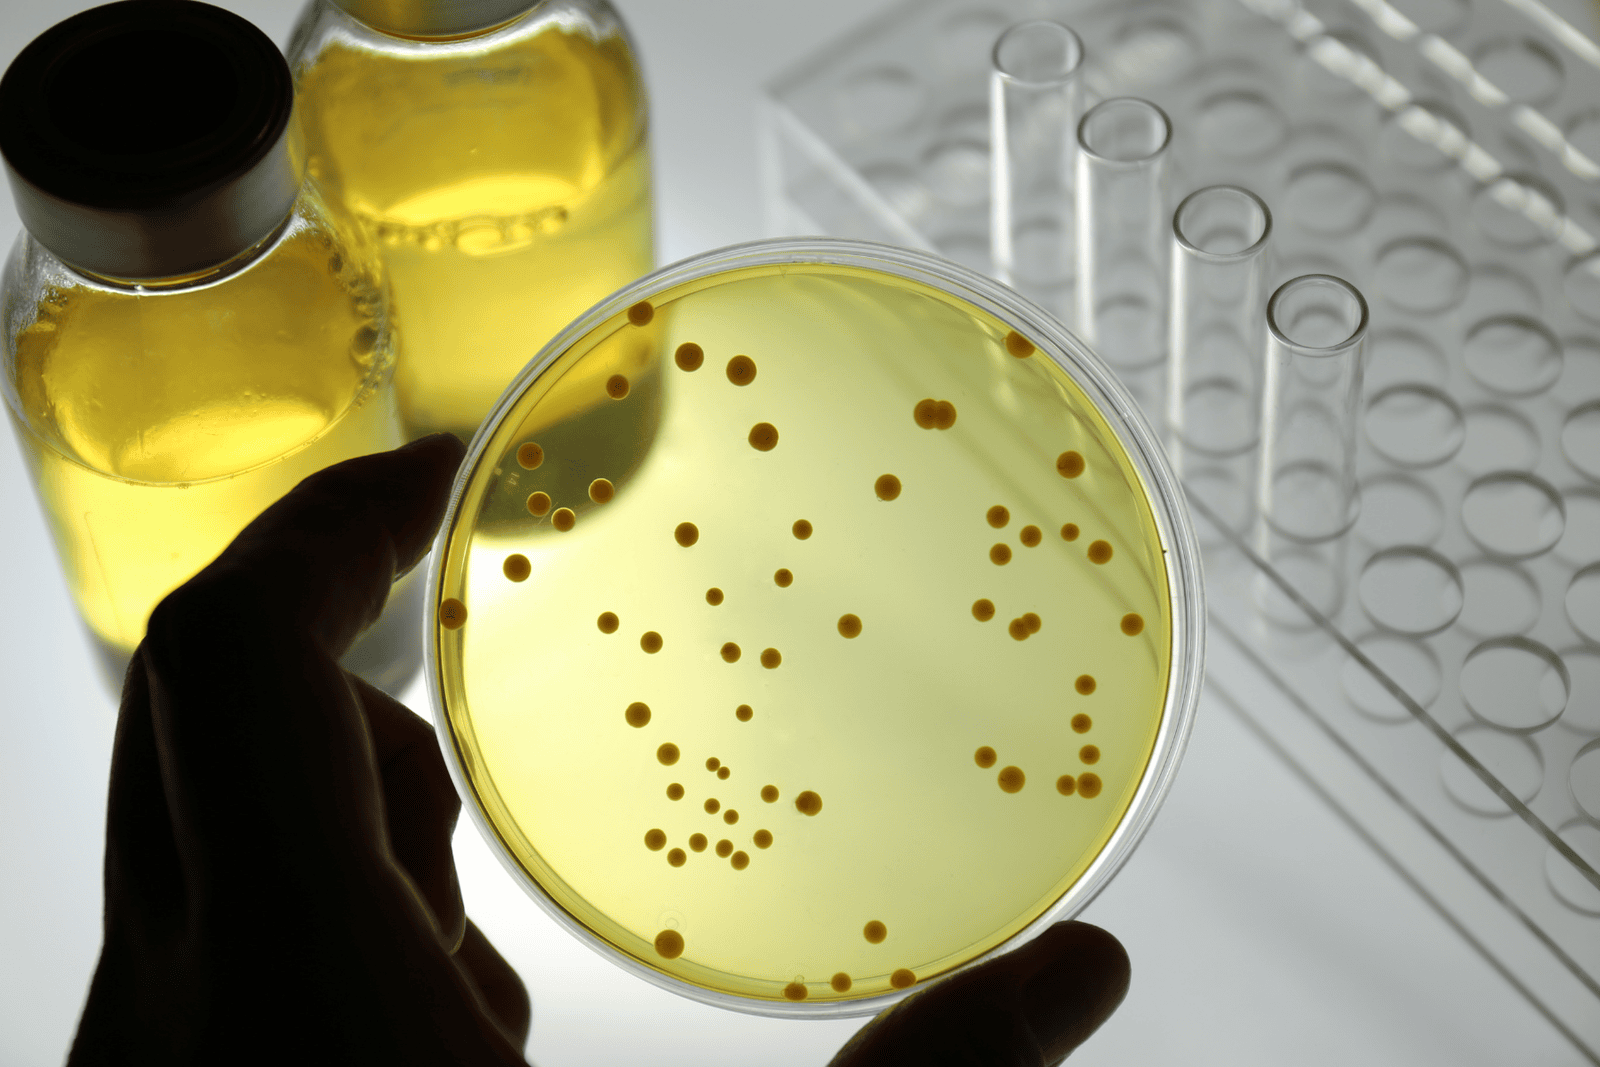
dravin enterprise

Welcome to
Dravin Enterprise
Our vision and mission is to be your helping hand for the supply of world class scientific products and services.
We offer cutting edge solutions for the Pharmaceutical Companies, Research Laboratories (R&D) and Clinical Research Organization (CRO).
Our Trusted Principals








Products and Services

Endotoxin Testing Reagents
We offer Lonza’s LAL and rFC reagents, engineered for precise and reproducible endotoxin detection across gel clot, kinetic, turbidimetric, and recombinant assay formats.
Reagents are available in a variety of sensitivities and configurations, tailored to meet the demands of sterility testing.

Pyrogen-Free Accessories
Support your LAL and rFC assays with Lonza's range of certified pyrogen-free accessories, including depyrogenated glassware, endotoxin-free pipette tips, dilution tubes, and reagent-grade water.
We offer:
Pyrogen Free Tips, Pyrogen Free Tubes, 96 Well Plates, Reagent Reservoirs, LAL Water.

Endotoxin Automation – PyroTec® PRO System
The PyroTec® PRO System (Lonza) enhances laboratory efficiency while strengthening compliance across your endotoxin testing workflows.
By adopting Lonza’s automation platform, you minimize human error and elevate the accuracy, consistency, and traceability of results—ensuring robust data integrity and regulatory confidence.

Microbiology Solutions
We bring you trusted microbiology solutions from Microbiologics USA, helping laboratories achieve accuracy, compliance, and confidence in every test. With validated QC organisms and reference materials, we make reliable results accessible to your team.

Sterilization & Cleaning Monitoring
We offer a comprehensive range of Biological and Chemical Indicators from Mesalabs, USA, specifically designed for routine monitoring of sterilisation and cleaning efficacy.
Available in multiple formats—strips, self-contained vials, liquid ampoules, stainless steel discs, and Bowie-Dick type tests—each product meets global standards for steam, EO, dry heat,
and hydrogen peroxide sterilization cycles.

Cleanroom Essentials
We offer a comprehensive range of cleanroom essentials including sterile and non-sterile garments, nitrile and latex gloves, cleanroom-compatible writing accessories (pens, markers, paper), autoclavable goggles, and a full spectrum of disinfectants such as IPA, hydrogen peroxide blends, and sporicidal agents.
Each product is validated for controlled environments, ensuring compliance with ISO and GMP standards while supporting contamination control across aseptic manufacturing, QC labs, and cleanrooms.

Genomics Services
We provide a comprehensive suite of Genomics Services including Custom Oligo Synthesis, PCR and DNA Sequencing, and 16S/18S rRNA-based Microbial Identification.
We offer advanced Next Generation Sequencing (NGS) platforms, which can support targeted, whole-genome, and metagenomic applications—delivering accurate, high-throughput data for research, diagnostics, and quality control. All services are backed by stringent QC, fast turnaround, and expert bioinformatics support.
Trusted by Industry Leaders












